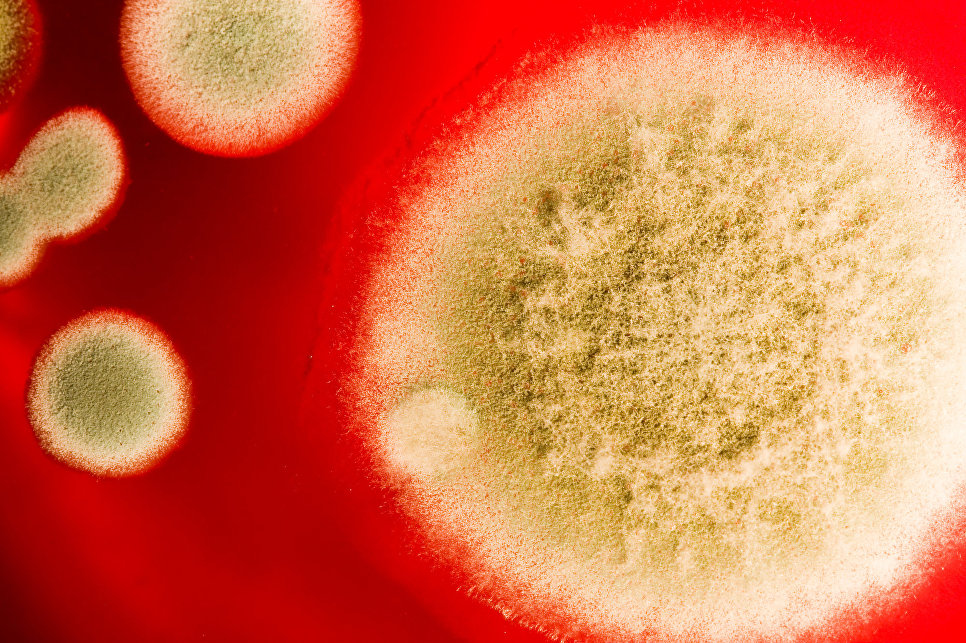

Ученые предсказали скорую и неизлечимую эпидемию
Невосприимчивый к лечению грибок может в скором времени привести к эпидемии, которая будет уничтожать растения, животных и людей. Об этом свидетельствует совместное исследование ученых из Имперского колледжа Лондона и Эксетерского университета, результаты которого опубликованы в научном журнале Science.
Согласно выводам специалистов, грибок вскоре может превратиться в подобие устойчивых к антибиотикам "супербактерий" и приобрести невосприимчивость к противогрибковым препаратам, которыми нередко злоупотребляют в медицине и сельском хозяйстве. В частности, этому способствует регулярное применение препаратов для лечения грибкового стоматита, эпидермофитии стоп, дерматофитии и онихомикоза.
При этом ученые отмечают, что угроза недооценена и вскоре даст о себе знать. По их словам, препараты уничтожают лишь слабые культуры грибков, а сильные выживают и эволюционируют, приобретая неуязвимость к противогрибковым препаратам. В связи с этим специалисты призывают к разработке средств, способных противостоять этой угрозе.
Исследователи также утверждают, что грибковые инфекции уносят больше жизней, чем рак молочной железы и малярия. Помимо этого, по их данным, смертность от болезней, вызванных грибками, сравнима со смертностью от туберкулеза и СПИДа.
ужасная новость?










Проголосуйте, чтобы увидеть результаты


Невосприимчивый к лечению грибок может в скором времени привести к эпидемии, которая будет уничтожать растения, животных и людей. Интересно было узнать, но лучше не думать!!! А вдруг ученые ошибаются..........
ученые порой бывают паникеры
Невосприимчивый к лечению грибок может в скором времени привести к эпидемии, которая будет уничтожать растения, животных и людей.
А может это происки изготовителей грибка, хим оружия и всякой другой дряни.Им обязательно нужно создать новую проблему, чтоб не расслаблялись
Да, жесть конечно! Грибок болезнь ужасная. И нельзя закрыть на это глаза. Если болит и ноет, тут уже точно не будешь терпеть сразу побежишь в больницу.Такое сразу надо лечить.Вот другое дело самолечение оно как раз может и навредить.
"Исследователи также утверждают, что грибковые инфекции уносят больше жизней, чем рак молочной железы и малярия. Помимо этого, по их данным, смертность от болезней, вызванных грибками, сравнима со смертностью от туберкулеза и СПИДа."
Грибки присутствуют с начала цивилизации. Только они мутируют.